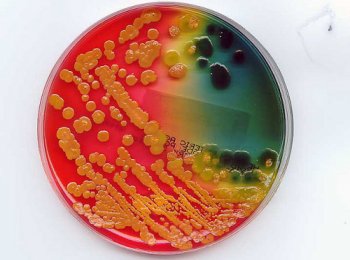

Agar bacteriologico - AIG Sinergia y Representaciones
Descripción de Agar bacteriologico - AIG Sinergia y Representaciones:
El agar bacteriológico se utiliza como agente gelificante en la preparación de medios de cultivo, así como en crecimiento y propagación in vitro de tejido vegetal.
El agar bacteriológico se utiliza como agente gelificante en la preparación de medios de cultivo, así como en crecimiento y propagación in vitro de tejido vegetal.

-
Cobertura de Agar bacteriologico - AIG Sinergia y Representaciones Nacional

-
Cobertura de Agar bacteriologico - AIG Sinergia y Representaciones Nacional
¿Necesitas una cotización personalizada?
Nuestro equipo técnico puede ayudarte a seleccionar Agar bacteriologico - AIG Sinergia y Representaciones ideal según tu línea de producción, velocidad y tipo de material.











